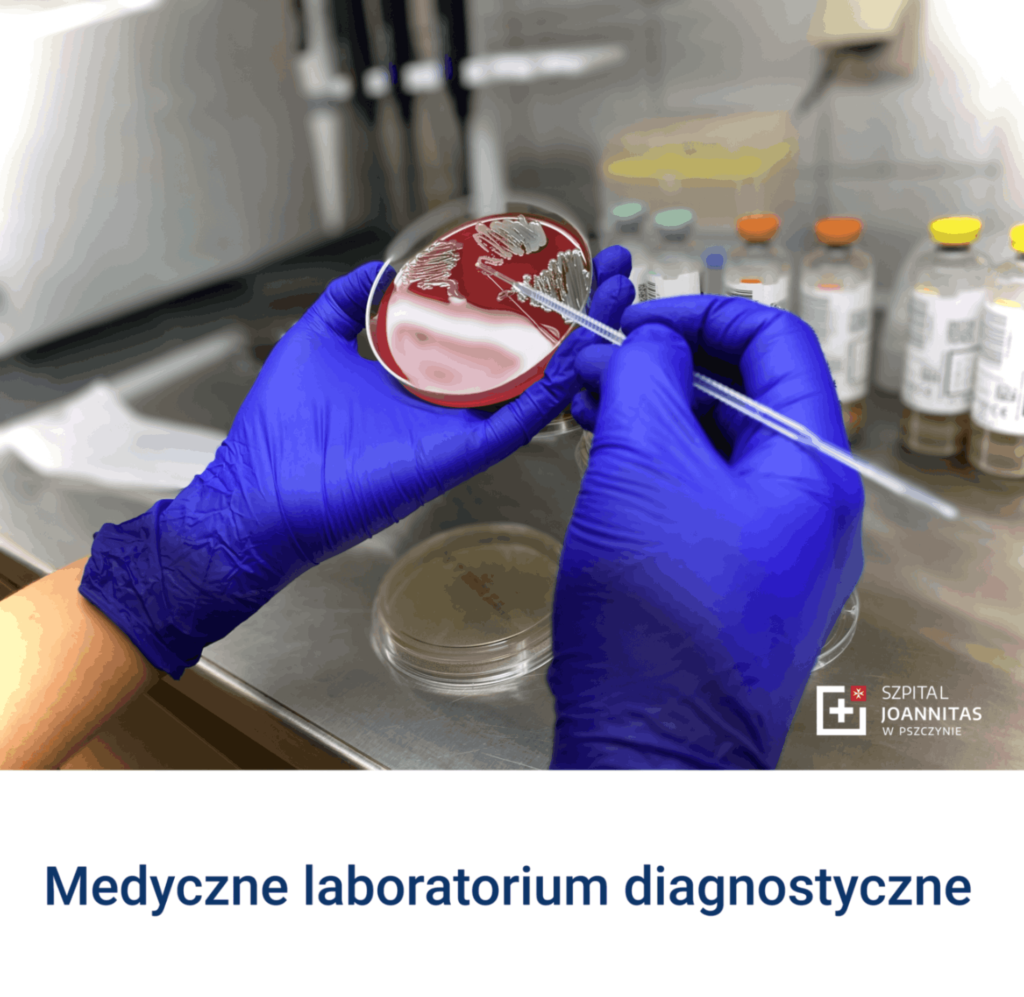

Kontakt 32 611 53 00 – Portiernia 32 611 53 07 – Izba przyjęć 32 611 53 01 – Nocna i świąteczna opieka
Adres ul. dr. W. Antesa 11 43-200 Pszczynakancelaria@szpital.pszczyna.pl
32 611 53 03 – Rejestracja poradni
32 611 53 04 – Rejestracja RTG, TK, USG MRI
32 611 53 05 – Laboratorium